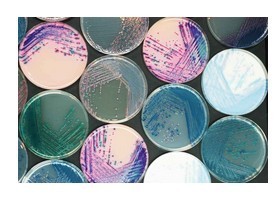
产品细节图片8

相关产品推荐更多 >
万千商家帮你免费找货
0 人在求购买到急需产品
- 详细信息
- 询价记录
- 文献和实验
- 技术资料
【产品名称】
李斯特菌显色培养基
【产品用途】
用于培养鉴别李斯特菌
【产品特点】
单核增生李斯特菌核伊氏李斯特菌有相似的生化特征,它们在传统培养基上是不能被区分的;
在科玛嘉显色培养基上,这二者可通过白色晕环来区分。
【贮存方法】
1. 干粉需储存于15-30℃环境中在有效期之前使用
2. 倾注好的培养基在室温可存放一天在2-8℃避光条件下可存放两星期。
【检验结果】
| 初筛微生物 |
菌落色彩 |
灵敏度 |
| 单核增生李斯特菌 |
蓝色,有白色晕环 |
近100% |
| 伊氏李斯特菌 |
蓝色 |
|
| 其他细菌 |
无色、或被抑制 |
|
【生产公司】
公司名称:南京便诊生物科技有限公司
地 址:南京市江宁区东山街道上元大街808号
联系电话:025-65016260,65016261,52838289,85099525,13951923346,18951960612
传 真:025-52838289
信 箱:njbianzhen@163.com
Q Q: 85026057 2232629373 945313800 QQ群:71118106(检验帝国)
网 址:www.njbianzhen.cn www.njbianzhen.com
【公司简介】
南京便诊生物科技有限公司是专业生产一次性成品培养基等微生物产品的专业性公司,质量参照新《中华人民共和国药典》2010年版、《国家食品药品检验标准》和《临床医学检验手册》的产品质量标准及检验方法执行,达到临床试剂要求。公司技术团队通过不断的改进生产工艺及生产设备,使其产品质量不断提高,得到很多新老客户的大力认可,并有很多老客户自发的帮我们介绍客户,在此,我代表我们公司全体人员向你们表示最真诚的感谢,同时我们会更加努力,进一步提高,推动微生物行业的发展,为我们各位检验人员提供方便、快捷、准确的产品!
我们为您提供专业的优质生化试剂;
具体的产品说明。。。。
更多的产品介绍。。。。。
请登陆南京便诊公司网站( www.njbianzhen.cn www.njbianzhen.com );
我们的淘宝网站: 双手指 淘宝店 http://shop67322957.taobao.com/
热线电话:
025 65016260,65016261,52838289,85099525,13951923346,18951960612;
我们将为您提供优质产品、贴心服务,让您省心、省时!
价格说明
- 一般情况下:
-
划线价格:划线的价格可能是商品的销售指导价或该商品的曾经展示过的销售价等,并非原价,仅供参考。
未划线价格:未划线的价格是商品在阿里巴巴中国站上的销售标价,具体的成交价格根据商品参加活动,或因用户使用优惠券等发生变化,最终以订单结算页价格为准。 - 活动预热状态下:
-
划线价格:划线的价格是商品在目前活动预热状态下的销售标价,并非原价,具体的成交价可能因用户使用优惠券等发生变化,最终以订单结算页价格为准。
未划线价格:未划线的价格可能是商品即将参加活动的活动价,仅供参考,具体活动时的成交价可能因用户使用优惠券等发生变化,最终以活动是订单结算页价格为准。
导购推荐






常见问题:
亲,低于500元请直接下单!
1:有发票吗?
答,默认不发发票,如果需要,在订单留言栏注明发票详细信息!(不再收费用)
2:是否有现货?
大部分现货,可以直接拍,标注无现货的,咨询客服发货时间!
3:下单后什么时候发货?
有现货,发货时间,当天15点之前下单付款的,当天发货;15点之后下单,次
天发货!由于库存处于动态变化中,部分若无现货,1—5天发货;紧急需要的,
务必联系客服,确认库存情况。
好评返现(打五星,15字以上好评,截图发过来,我们登记,返现3元),拒绝
差评哦,谢谢你的支持额!
咨询电话:025-52838289(便诊总机)


运费有疑问时咨询客服!


南京便诊 专注微生物
南京便诊 谁用谁方便
 |
||
 |
 |
 |
 |
 |
 |
 |
 |
 |
风险提示:丁香通仅作为第三方平台,为商家信息发布提供平台空间。用户咨询产品时请注意保护个人信息及财产安全,合理判断,谨慎选购商品,商家和用户对交易行为负责。对于医疗器械类产品,请先查证核实企业经营资质和医疗器械产品注册证情况。
- 作者
- 内容
- 询问日期
 文献和实验
文献和实验的氯、氨或金属离子 • 水电导率应小于25 μS/cm,最好小于5 μS/cm • 建议使用新鲜纯化的水,或将水储存在不含抑制物质的容器中 • 水中微生物污染应小于103 cfu/mL 微生物学家只要在培养基的制备过程中遵循这些纯水标准,就能提升其微生物培养物的可靠性和重现性。 Milli-Q® IX纯水系统运用了创新水纯化技术,能够稳定提供高质量的纯水,满足微生物培养基制备要求。此外,该系统产水还能供给实验室设备,如高压灭菌器或洗瓶机,是实现微生物实验室多位一体布局的优质纯水
【公告】丁香通试用中心:10月免费试用装精选(10月18日有更新)
200ul低吸附盒装吸头 进口TS3000转染试剂 纳米微粒 非脂质体 其他推荐: 单组分TMB显色液 Peroxidase Conjugated Goat Anti-Rabbit IgG (Min Hu, Ms) 二抗 96通道个人型半自动移液系统 小动物气体麻醉机,大小鼠气体吸入式麻醉机 四通道实时荧光定量PCR检测系统 Tanon-5200化学发光成像系统(包邮) 优质微晶纤维素MCC(进口) 罗恩1-10ml电动移液器 EpiScript逆转录酶 western
)测量各孔的吸光值。5)同时设置调零孔(培养基、MTT、二甲基亚砜),对照孔(细胞、相同浓度的药物溶解介质、培养液、MTT、二甲基亚砜),每组设定3复孔。MTT的配制MTT一般最好现用现配,过滤后4ºC避光保存两周内有效,或配制成5mg/ml保存在-20度长期保存,避免反复冻融,最好小剂量分装,用避光袋或是黑纸、锡箔纸包住避光以免分解。我一般都把MTT粉分装在EP管里,用的时候现配,直接往培养板中加,没必要一下子配那么多,尤其当MTT变为灰绿色时就绝对不能再用了。MTT有致癌性,用的时候小心,有条件
 技术资料
技术资料暂无技术资料 索取技术资料